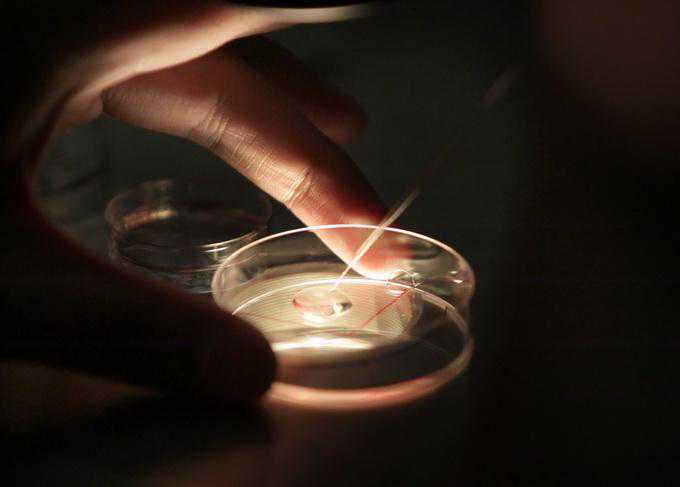

判决书显示,李某诉称,南宁市第二人民医院(以下简称“市二医院”)在他没有提供任何证明文件、未办理任何手续的情况下,就把胚胎移植给其前妻陆某,致使陆某生下双胞胎男孩,他因此被认定为超生,被开除公职。
图文无关资料图,北晚新视觉供图
2019年底,广西一公务员李某因婚外生育被开除公职,孩子是其前妻通过试管婴儿助孕生下的,做手术时,两人已经离婚。被开除后,李某将手术医院告上法庭,称其违规手术,致使他被开除,要求医院赔偿1万元精神抚慰金。
近日,该案一审判决公布,李某的诉讼请求被法院驳回。
该案的一审法院为广西壮族自治区南宁市江南区人民法院。判决书显示,李某诉称,南宁市第二人民医院(以下简称“市二医院”)在他没有提供任何证明文件、未办理任何手续的情况下,就把胚胎移植给其前妻陆某,致使陆某生下双胞胎男孩,他因此被认定为超生,被开除公职。李某认为,医院不严格审查材料的不负责任的行为,造成他被开除,这对他和家人的精神打击很大,请求法院判令市二医院赔偿其精神抚慰金1万元。
审理中,市二医院称,李某与陆某曾三次到该院生殖中心就诊,要求试管婴儿助孕,分别是2004年6月、2008年6月、2010年7月,第三次成功,陆某于2011年3月产下二子。该院生殖中心每次都按规定审查了李某与陆某相关证明材料,并保留有复印件,李某与陆某也签署有《胚胎解冻和移植知情同意书》。但李某与陆某在2010年隐瞒了婚姻关系,并且还提供了“生育审查证明”原件。
市二医院提交了两人的结婚证复印件作为证据。法院认为,2010年7月时李某与陆某已经处于离婚状态,按照常理李某与陆某的原结婚证应该印有“作废”字样,但医院提供的结婚证复印件上并没有“作废”字样。
对此,李某称,结婚证在陆某处,他以为离婚了签个字没有问题,医院不可能帮做这个手术。
此外,市二医院提供的证据中,还有一份南宁市良庆区南晓镇计划生育办公室于2010年5月20日出具的《生育审查证明》,主要内容为证明李某与陆某于1998年10月23日结婚,二人符合国家人口计划生育政策,准许生育第壹孩,该证明加盖有出具单位公章。
审理中,市二医院称,作为医疗机构,医院只对当事人提交的材料真实性进行一般审查,当事人提交伪造或虚假的证明或故意隐瞒婚姻状况,医院没有能力查实。
法院经审理认为,李某和陆某没有如实向医院告知真实的婚姻状况,且故意提供了形式上真实但内容与事实不符的相关证明材料,医院在审核相关材料的过程中并无过错。此外,法院还认为,李某作为曾经的公务员,其对婚外生育可能产生的不良影响和不利后果应有明确的认知。
综上,法院认为李某的诉求没有事实和法律依据,对其因婚外生育受到计生罚款及政务开除处分的后果,医院没有过错。最终,法院判决,驳回李某的全部诉讼请求。
流程编辑:TF006免责声明:本文章如果文章侵权,请联系我们处理,本站仅提供信息存储空间服务如因作品内容、版权和其他问题请于本站联系